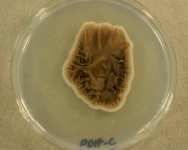
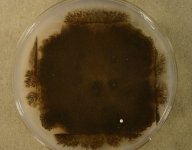
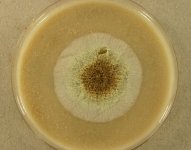
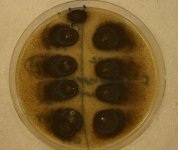
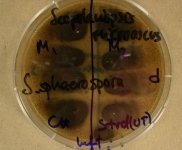

<< back to search
IMAGES:

Search Details
add to cart
| UAMH Number: | 11533 |
|---|---|
| Species Name: | Scopulariopsis asperula |
| Type: | |
| Synonyms: | Acaulium nigrum / Acaulium nigrum var. glabrum / Microascus niger / Monilia arnoldii / Penicillium nigrum / Penicillium repens / Phaeoscopulariopsis bestae / Scopulariopsis arnoldii / Scopulariopsis bestae / Scopulariopsis fusca / Scopulariopsis ivorensis / Scopulariopsis repens / Scopulariopsis roseola / Torula asperula / Torula bestae |
| Taxonomy: | FUNGI Ascomycota, Sordariomycetes, Microascales, Microascaceae |
| Strain History: | Andersen, B. (d/d) -> UAMH |
| Substrate: | passive air sample (60 min on V8-dichloran medium), living room of home; 4 colonies isolated from original plate and then self-crossed | Location: | DENMARK Lyngby (GEO: 55.764,12.495) |
| Isolator: | B. Andersen |
| Isolation Date: | 2011-02-28 |
| Date Received: | 2011-07-12 |
| Characters: | BIODIVERSITY indoor air fungi - // CULTURE CONDITIONS ascomata observed on original plate but ascomata with ascospores not produced in subculture - (Click for publications citing UAMH 11533) |
| Compounds: | |
| Cross Reference: | |
| Collections: | Living Strains; Dried Herbarium Material |
| Pathogenic Potential: | Human: yes | Animal: yes | Plant: no |
| Biosafety Risk Group: | RG2 (check the PHAC ePATHogen Risk Group Database for updates) |
| Regulatory Requirements: | Canadian requesters must provide PHAC Pathogen and Toxin License Number (see: https://www.canada.ca/en/public-health/services/laboratory-biosafety-biosecurity/licensing-program.html) and a CFIA Written Authorization for transfer (http://www.inspection.gc.ca/plants/plant-pests-invasive-species/directives/date/d-12-03/eng/1432656209220/1432751554580#app2) prior to shipment. International requesters must provide all legally required importation documentation prior to shipment. Plant pathogenicity status may be verified by using the USDA Agricultural Research Service (ARS) Fungal Database |
| MycoBank ID: | 305670 |
IMAGES: